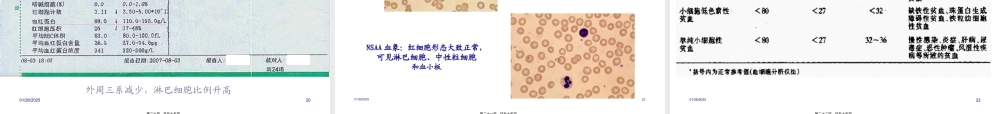
再生障碍性贫血(教学).pptx

河南中医学院一附院01/26/20251第一页,共五十五页。1.掌握再障的临床表现和血液学特点,诊断依据和鉴别诊断,治疗方法2.熟悉再障的病因、骨髓特征性病理改变3.了解再障发病机制目的和要求01/26/20252第二页,共五十五页。概念指原发性骨髓造血功能衰竭综合征。主要表现为骨髓造血功能低下、全血细胞减少和贫血、出血、感染,免疫抑制剂治疗有效。01/26/20253第三页,共五十五页。01/26/20254第四页,共五十五页。根据患者的病情、血象、骨髓象及预后分重型〔SAA〕和非重型〔NSAA〕。国内曾将AA分为急性型〔AAA〕和慢性型〔CAA〕。后将AAA改称为重型—I型〔SAA-I〕,将CAA进展成的急性型称为重型再障—II型〔SAA-II〕01/26/20255第五页,共五十五页。流行病学01/26/20256第六页,共五十五页。发病率:我国为7.4/10万,日本为14.7-24.0/10万,西方为4.7-13.7/10万。老年人发病率较高;无明显性别差异。01/26/20257第七页,共五十五页。病因和发病机制一、病因:①病毒感染;肝炎病毒、微小病毒B19等.临床上可见到乙型肝炎相关的再生障碍性贫血病例。②化学因素;特别是氯霉素类抗生素、磺胺类药物、抗肿瘤化疗药物以及苯等。01/26/20258第八页,共五十五页。③物理因素:长期接触X射线、镭及放射性核素等可影响DNA的复制,抑制细胞有丝分裂,干扰骨髓细胞生成,造血干细胞数量减少。④其他:如PNH、妊娠等,再障可发生在妊娠期,有时在分娩、自然流产、引产后可缓解。有1/3PNH患者可发生全血细胞减少。⑤一定遗传背景01/26/20259第九页,共五十五页。发病机制造血干祖细胞缺陷种子造血微环境异常土壤免疫异常虫子01/26/202510第十页,共五十五页。〔一〕造血干、祖细胞缺陷:含量与质的异常:量:AA者骨髓CD34+细胞明显减少,且与病情正相关。质:AA造血干祖细胞集落形成能力显著降低;对造血生长因子反响差;免疫抑制治疗后恢复造血不完整;局部AA有单克隆造血证据并可向PNH、MDS甚至白血病转化。01/26/202511第十一页,共五十五页。〔二〕造血微环境异常:活检发现造血细胞减少外,还有髓脂肪化、静脉窦壁水肿、出血、毛细血管坏死;基质细胞培养生长情况差,分泌的各类造血调控因子不正常;有基质细胞受损的AA作HSCT不易成功。01/26/202512第十二页,共五十五页。〔三〕免疫异常:AA者淋巴细胞比例增高;T细胞亚群失衡,T4/T8↓;T辅助性细胞I型CD8+T抑制细胞、CD25+细胞和γδTCR+T细胞比例增高;T细胞分泌的造血负调控因子明...